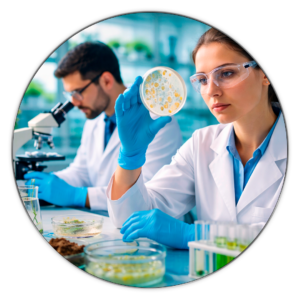
Nuestros-Servicios-Ecoseram-Microbiología-Ambiental-Colombia

Servicios ambientales, Soluciones en saneamiento básico, Consultoría ambiental y productos para Laboratorio
ECOSERAM
¿por qué escogernos?
Brindamos soluciones confiables en servicios ambientales, productos para laboratorio, saneamiento básico y asesoría técnica, garantizando cumplimiento normativo, seguridad y atención personalizada.